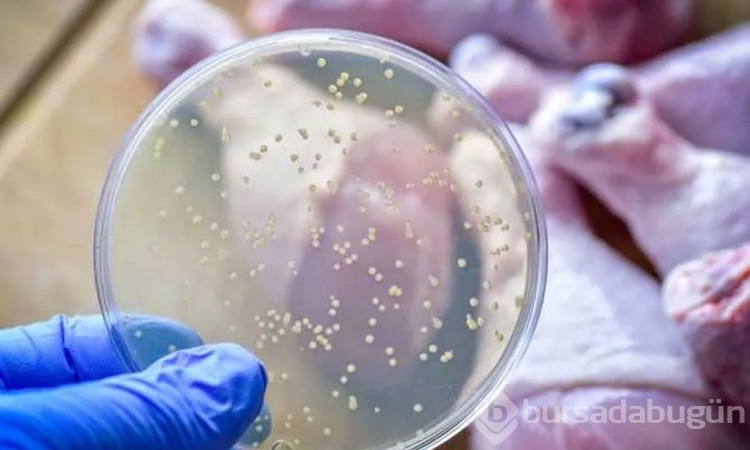

Kinder'den binlerce kişiye bulaşmıştı!
Çikolata üreticisi Ferrero'nun Kinder Sürpriz ve diğer ürünlerinde ortaya çıkan Salmonella bakterisi bir çok ülkede görülmüş binlerce kişi ve özellikle çocuklar hastanelik olmuştu. Yeni yapılan araştırmaya göre şimdi de baharat kutularında Salmonella bakterisi tehlikesi var.
"ARAŞTIRMA TEHLİKELİ SONUÇLARI GÖSTERDİ"
Katılımcılara mutfak alanlarının daha sonra kontaminasyon açısından test edileceği konusunda bilgi verilmedi. Yemek için kullanılan öğütülmüş hindi, bir bölgeyi kirlettiğinde Salmonella'ya benzer şekilde hareket edecek bir kimyasal içermek üzere önceden müdahale edilmişti.
Daha sonra, Salmonella'nın varlığını test etmek için mutfaklar temizlendi. Fakat elde edilen verilere göre; yaygın kirlenmeye sahip nesne baharat kaplarıydı. Bunların yaklaşık yarısında, yüzde 48'inde madde bulundu.
Son Güncellenme: 2022.10.21 09:49
Kategori: Yaşam
Öne Çıkan Galeriler